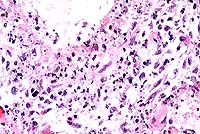

AFIP Diagnosis: Lung: Pneumonia, bronchointerstitial, necrotizing, subacute, diffuse, moderate to severe, with intranuclear inclusion bodies, breed unspecified, feline, etiology consistent with feline herpesvirus 1.
Signalment: 14-day-old, female, kitten (Felis catus).
History: Approximately two weeks after birth, two previously healthy female kittens housed in a biomedical research facility had acute onset of respiratory distress. On auscultation, the veterinarian detected moist rales and crackling throughout the lungs. Treatment with antibiotics proved ineffective. The kittens became depressed; the kitten used in this case died within 24 hrs of the onset of clinical signs. The other kitten died the following day.
This litter of two kittens was born to a primipara queen used in a study of fetal alcohol syndrome. The queen was purchased for the study 11 months previously from a Class A vendor. She had been born in the vendor's colony (which was advertised as ‘disease-free') and had been vaccinated against feline calicivirus, feline parvovirus (panleukopenia), feline herpesvirus type 1 (Feline Viral Rhinotracheitis), Chlamydia psittaci , and rabies. While on study, she was fed a fatty acid (docosahexaenoic acid) deficient diet, received alcohol-filled capsules, and was bred to one of the research facility's toms. After parturition, she and her kittens were housed in a separate room and had no contact with other cats. At no time during the study did the queen manifest any clinical abnormalities, and no other cats in the colony exhibited similar disease.
Gross Pathology: At necropsy, the kitten was found to be in good flesh, with an empty stomach, and yellow, pasty feces in the colon. The cranial lung lobes were congested and consolidated.
Laboratory Results: Bacterial culture of the lung was negative.
Contributor's Diagnosis and Comments: Lung: Pneumonia,
broncho- interstitial, multifocal, acute, severe, necrotizing,
with intranuclear viral inclusions.
Etiology: feline herpesvirus-1 (feline rhinotracheitis virus)
The kittens died of severe necrotizing pneumonia caused by
feline herpes- virus (FHV-1) infection. Significant microscopic
changes were confined to the lungs. Multifocally, bronchi and
bronchioles were necrotic and filled with fibrin, neutrophils
and cellular debris. There was multifocal patchy necrosis of alveoli,
with flooding of lumina with fibrin and cellular debris. In less
affected areas, alveolar septa were thickened by neutrophils,
fibrin and edema, with numerous microthrombi within alveolar capillaries.
Alveolar lumina contained small to moderate numbers of neutrophils
and fibrin. The stroma surrounding arteries and arterioles was
edematous and infiltrated by lymphocytes, macrophages and neutrophils.
The pleura was multifocally thickened by macrophages, neutrophils
and fibrin. Nuclei of remaining airway epithelial cells were occasionally
cleared, with margination of the chromatin and smudgy to discrete
eosinophilic inclusions. Indistinct, smudgy eosinophilic inclusions
were also found in scattered alveolar septal cells, surrounded
by a dark rim of marginated chromatin. Necrotizing bronchitis,
bronchiolitis and pneumonia with intranuclear eosinophilic viral
inclusion bodies are diagnostic of that agent. Transmission electron
microscopy on formalin fixed tissue was used to confirm the diagnosis;
typical 100-105 nm unenveloped icosahedral viral particles were
readily demonstrated in bronchial epithelial cell nuclei. In some
of the sections, typical type A Cowdry inclusions were difficult
to identify, due to the extensive necrosis of the bronchial/bronchiolar
epithelium.
The differential diagnosis for feline pneumonia should include
other viral agents, bacteria, chlamydia, fungi, protozoan and
metazoan parasites, and foreign body/aspiration pneumonia. Toxoplasma
gondii can cause necrotizing pneumonia; microscopic diagnosis
is based on finding typical clusters of basophilic round zoites
within cells. Calicivirus infection is usually limited to the
upper respiratory tract; however, some strains have a strong tropism
for alveolar type I pneumocytes, and result in interstitial pneumonia.
However, bronchial and bronchiolar epithelium is generally spared,
and intranuclear inclusions are not present. Primary bacterial
pneumonia is encountered uncommonly in the cat. Chlamydia psittaci,
generally a cause of feline conjunctivitis, can cause a mild bronchointerstitial
pneumonia which, in the absence of secondary bacterial infection,
is self-limiting. It does not cause severe necrosis or intranuclear
inclusions. In mycotic or parasitic pneumonia, the etiologic agent
is readily identified in section. In pneumonia caused by either
aspiration of stomach contents or inadvertent administration of
material into the lungs via a misplaced stomach tube, the inflammatory
infiltrate would contain a significant population of macrophages
and foreign material may be visible grossly or microscopically.
In the case of agents with a high lipid content (milk or mineral
oil, for example), macrophages would contain prominent empty vacuoles,
representing lipid removed during processing of the tissue. Lipid
can be demonstrated with frozen sections stained with Sudan black
or oil red O histochemical stains.
FHV-1 infection in cats generally results in rhinotracheitis,
an upper respiratory tract disease with virus replication occurring
primarily in the epithelium of the nasal passages, pharynx, soft
palate, conjunctiva, tonsils, and trachea. After an incubation
period of 2 to 6 days, the virus replicates in and lyses permissive
cells, resulting in epithelial necrosis and formation of intranuclear
inclusion bodies. Clinically, the disease is characterized by
fever, salivation, sneezing, coughing, oral respiration, and serous
to mucopurulent nasal and ocular discharges. Virus is shed in
these secretions, and is the usual route of transmission via nose
to nose contact or sneezed droplets. Most cats recover in 7 to
14 days, but mortality can occur in infants or immunosuppressed
older animals. In kittens, ocular involvement (conjunctivitis
neonatorum) can result in ulcerative keratitis, panopthalmitis,
and blindness. Rarely the virus can cause severe fatal pulmonary
disease, characterized by necrotizing bronchitis, bronchiolitis,
and pneumonia, with serofibrinous flooding of alveoli and airways
in young kittens and other susceptible animals. Experimental infections
can cause systemic disease, fatal encephalitis, and abortions;
these complications occur rarely in natural infections. Like other
herpesviruses, FHV-1 can cause a latent infection, with the virus
residing in the trigeminal ganglia, optic nerves, olfactory bulbs,
and corneas. Stress and other factors, including corticosteroid
injections, can trigger intermittent viral shedding by these carrier
animals.
Although the queen in this case had a history of FHV-1 vaccination, she was likely a carrier. The vendor colony had experienced an outbreak of feline herpesvirus disease in 1994, which had not been fully eradicated. The queen was probably infected prior to vaccination, and subsequent vaccination would be ineffectual in eliminating the latent infection. The stress of pregnancy and lactation likely resulted in recrudescence and viral shedding. Shedding queens can infect their litters via grooming, nose to nose contact, sneezed nasal secretions, or through the milk. The severe pneumonia and absence of lesions in the upper respiratory tract suggest these kittens may have been infected via inhalation of aerosolized viral particles released by the queen by sneezing.
Conference Note: In addition to cats, several domestic animal species are susceptible to respiratory infections caused by alphaherpesviruses. Canine herpesvirus 1 causes a highly fatal systemic disease in neonatal dogs, characterized by necrotizing vasculitis in multiple organs, especially lung, liver, and kidney. Equine herpesvirus 1, which is an important cause of abortion, encephalomyelitis, and neonatal foal mortality, causes an acute necrotizing interstitial pneumonia in neonatal foals. Equine herpesvirus 4 (rhinopneumonitis virus) causes predominantly respiratory disease that is independent of abortions and is seen mostly in weanling foals during autumn. This disease is characterized by slight fever, serous or catarrhal rhinitis, and conjunctivitis. Bovine herpesvirus 1 causes infectious bovine rhinotracheitis in cattle, characterized by inflammatory lesions in the upper respiratory tract, trachea, and conjunctiva. Certain strains of porcine herpesvirus 1 (pseudorabies, Aujeszky's disease) can cause rhinitis and pneumonia in swine, characterized by hemorrhagic consolidation of cranioventral regions of the lung, with necrosis in bronchioles and adjacent alveoli as the principal histologic feature.
Feline herpesvirus 2, also known as feline cell-associated herpesvirus (FeCAHV), has been implicated along with other viruses as a causative agent in the etiopathogenesis of some forms of feline lower urinary tract disease. Kruger et al7demonstrated through genetic and serologic studies that FeCAHV is a strain of bovine herpesvirus 4.
Contributor: Veterinary Resources Program, National Center for Research Resources, National Institutes of Health, Bethesda, MD 20892-5230.
References:
International Veterinary Pathology Slide Bank:
Laser disc frame #15417.
Signalment: 13-year-old, 2.65 kg, female, spayed, Domestic Shorthair cat.
History: The cat presented to the veterinarian with a 2-week history of icterus and a longer history of polyphagia and weight loss. Physical exam revealed a large abdominal mass and ascites. Radiographically, the mass appeared to be in the area of the kidneys and ultrasound revealed a cystic mass extending from the liver to the kidneys. The cat was taken to surgery, the mass was deemed unresectable, and the cat was euthanatized.
Gross Pathology: At necropsy, the mucous membranes, subcutaneous fat deposits, abdominal fat and pericardial fat were markedly icteric. The liver was diffusely red-orange and weighed 120 grams (4.5% of body weight). There was a diffuse, slightly enhanced reticular pattern. The pancreas was largely replaced by a 10.5 cm-long, 1.0-2.5 cm-diameter, firm, tan mass composed of multiple tubular cystic loci (consistent with antemortem ultrasound). This lesion was removed at surgery and submitted separately.
Laboratory Results:
Alk Phos 274 (N=15-55) IU/L
ALT 710 (N=20-75) IU/L
AST 237 (N=0-100) IU/L
T. BiL 9.8 (N=0-0.1) mg/dL
Glob 6.0 (N=2.1-5.1) g/dL
T. prot 8.8 (N=6-8) g/dL
Cytology: Aspiration of the mass was inconclusive, showing nondegenerate PMN's, occasional small lymphocytes, few monocytes and eosinophils as well as sheets of uniform epithelium characterized by oval nuclei, 1-2 nucleoli and moderate amounts of basophilic cytoplasm with numerous small vacuoles.
Contributor's Diagnosis and Comments: Liver: Severe chronic diffuse bridging lymphocytic pericholangitis and hepatitis. Pancreas (sections not submitted): Severe chronic diffuse sclerosing lymphoplasmacytic pancreatitis with marked multifocal ductular ectasia.
The findings in this case are consistent with feline progressive cholangitis. According to Lucke and Davies (1984), cats usually present with ascites, jaundice, polyphagia and weight loss; some cats are anorexic. In the same study, cats had unremarkable serum biochemistries with the exception of mildly to moderately increased alkaline phosphatase activities in 12 of 21 cats, and mild to marked increases in conjugated bilirubin in 6 cases.
Gross findings of feline progressive cholangitis consist of a normal to enlarged liver, an enhanced reticular pattern and variably present hepatic nodular change. Histologically, there is prominent lymphocytic infiltration and fewer numbers of other leukocytes. Other changes can include bile duct destruction and/or proliferation, and fibrosis with vascular changes similar to those seen in cirrhosis.
Due to the normal anatomic fusion of the feline pancreatic and biliary ducts proximal to the duodenum, feline hepatobiliary disease may be seen in conjunction with chronic pancreatitis and obstruction. The cat in this case had a severe sclerosing pancreatitis of unknown etiology.

Conference Note: Feline cholangitis/cholangiohepatitis has been described as a disease complex including three characteristic histologic lesions, each presumably reflecting progressive stages of one disease.4 In this report, suppurative cholangitis/cholangiohepatitis, characterized by periportal and hepatic parenchymal infiltration of neutrophils with bile duct hyperplasia, mild fibrosis, and filling of bile ducts with inflammatory cellular debris, was considered the earliest of the three lesions. Long-term inflammation associated with progression of this condition reportedly led to nonsuppurative cholangitis/cholangiohepatitis, with the characteristic histologic findings of lymphocytic and plasmacytic periportal inflammation, bile duct hyperplasia, and periportal fibrosis. Biliary cirrhosis, with severe portal fibrosis, bile duct hyperplasia, nodular hepatic hyperplasia, and a variable degree of chronic inflammation, was presumed to be the end-stage result of long-term cholangiohepatitis in some cats.
In a recent retrospective study, Gagne et al5 described three subclassifications of feline inflammatory liver disease based on the predominant cell type within portal areas, i.e. lymphocytic-plasmacytic, neutrophilic, and mixed. Lymphocytic portal hepatitis was characterized by portal infiltration of lymphocytes and plasma cells, without neutrophils or macrophages. Inflammation was restricted to the portal area and did not extend into hepatic parenchyma. Lymphoid follicles were occasionally found. Bile duct proliferation and portal or portal-bridging fibrosis were present in most cases, but neither biliary epithelial degeneration nor inflammatory cells in bile ducts was seen. Cats with neutrophilic portal hepatitis had primarily neutrophils, with varying numbers of lymphocytes and plasma cells, present within portal areas. Periportal hepatocellular necrosis was a common finding, as was bile duct epithelial degeneration, necrosis, inflammatory cell infiltrate, and duct proliferation. Portal and portal bridging fibrosis was common. Cats with mixed portal hepatitis had approximately equal numbers of lymphocytes/plasma cells and neutrophils. In this third group of cats, associated histologic changes were similar to those with predominantly neutrophilic portal infiltrates. The authors propose using the term lymphocytic portal hepatitis for those cases characterized by lymphocytic/plasmacytic inflammation confined to the portal areas, and that hepatitis characterized by cholangitis and portal neutrophilic infiltrates with or without lymphocytes and plasma cells be termed cholangiohepatitis.
Contributor: University of Tennessee Veterinary Teaching Hospital, 2407 River Drive, Room A201, Knoxville, TN 37996-4500.
References:
International Veterinary Pathology Slide Bank:
Laser disc frame #5433-7, 13096, 16360, 16361
Signalment: 16-year-old, female, spayed, Dachshund, canine.
History: This animal was presented for bilateral serous nasal discharge and open-mouthed breathing. Thoracic radiographs revealed left heart enlargement with severe bilateral pulmonary edema and generalized hepatomegaly. She was treated with furosemide, nitroglycerin, and supplemental oxygen. She subsequently went into respiratory arrest and died.
Gross Pathology: A cosmetic necropsy was performed.
The heart was enlarged, globoid, and had two apices. Both ventricles
were markedly dilated and there was moderate nodular thickening
of the mitral valve leaflets. All lung lobes were red, with irregular,
1-3 mm diameter, pale, patchy areas, and oozed serosanguineous
fluid from cut surfaces. Intestinal vessels were prominent and
congested. The liver was enlarged and weighed 500 grams (8.3%
of body weight). The gall bladder contained an 8 mm3 spiny black
concretion. There was a
15 x 6 x 6 mm, pale, firm, well-circumscribed mass in the pylorus.
Laboratory Results:
Contributor's Diagnoses and Comments:

Conference Note: Conference participants discussed the interesting histologic findings which, along with the history, suggest the superimposition of an acute infectious process upon the chronic secondary pulmonary effects of cardiac insufficiency in this dog. The predominantly neutrophilic inflammation suggests bacterial infection. Interstitial fibrosis is likely a result of long-term pulmonary congestion. It is unclear as to what type of amyloid is involved in the vascular amyloid deposits of the dog. Some believe it may be reactive amyloidosis; however, recent articles state that the amyloid deposits are a senile form of amyloidosis. The precise pathogenesis is unclear. Recent articles describe this amyloid as apolipoprotein A1-derived vascular amyloidosis. Mild pulmonary vascular amyloidosis is frequently observed in aged dogs. Participants agreed that the severity of the lesion in this case is unusual.
History: Abattoir specimen taken for routine screening of flocks for Johne's disease.
Gross Pathology: The distal ileum and proximal colon were thickened and edematous and the ileocecal lymph node was enlarged.
Laboratory Results: None.
Contributor's Diagnosis and Comments: Enteritis, granulomatous, diffuse, chronic, severe, with diffuse granulomatous lymphadenitis and multifocal lymphogranulomatous phlebitis, lymphangitis and arteritis, mixed breed, adult ovine, caused by acid-fast bacilli, Mycobacterium avium var paratuberculosis, Johne's Disease.
In this case, there is extensive atrophy of normal mucosal
components, which are replaced by an extensive infiltrate of macrophages
into the lamina propria and submucosa, and also with variable
numbers of lymphocytes, plasma cells, neutrophils and eosinophils,
and generally low numbers of Langhans giant cells and epithelioid
macrophages. Peyer's patches are hyperplastic, and mesenteric
attachments are edematous. There are nodular areas of vasculitis
and lymphangitis (not present in all sections). Although the surface
epithelium is absent in most areas, this is interpreted as an
artifact associated with autolysis and not an ulcerative process.
The macrophages throughout the intestinal lesions are distended
with mycobacteria, confirmed by Ziehl Nielsen stains, but apparent
as fine basophilic cytoplasmic stippling in H&E-stained sections.
The lesions are typical for the so-called lepromatous or multibacillary
form of ovine Johne's disease (JD). A second form of the disease
in small ruminants, the paucibacillary form, has few organisms,
few infected macrophages and the inflammatory lesions are predominantly
lymphocytic rather than granulomatous. In this second form, the
diagnosis may be difficult to confirm, either by histopathology
or by culture.
JD was initially recognized as an important disease of cattle,
and more recently of small ruminants, including sheep, goats,
alpacas and deer. In sheep, early lesions are rarely associated
with diarrhea and intestinal lesions may be multifocal and irregular
rather than the diffuse terminal ileitis seen in cattle. In advanced
cases in small ruminants, weight loss and decreased milk and meat
production are more common than diarrhea.
There are strain difference in M. paratuberculosis between the bovine and small ruminant isolates, and ovine isolates are more difficult to culture, making confirmation, particularly of paucibacillary cases, diagnostically challenging. Because of the similarity of histologic lesions between JD of ruminants and Crohn's disease of humans, a possible causal relationship has long been suspected but is as yet unproven. The disease can be transmitted experimentally to rabbits, but whether this species serves as a natural reservoir to maintain and disseminate the disease amongst ruminant species is not yet clear. In many countries, JD is endemic amongst sheep flocks and eradication is considered impractical. In Australia, the incidence of JD in sheep flocks is low, and recently eradication programs have been introduced. This animal was identified at slaughter as a probable JD case and came from a flock known to be infected. Obviously, the role rabbits potentially play in acting as reservoir hosts for JD is of significance to recently instituted eradication programs in Australia.


Conference Note: Some sections viewed in conference contain small numbers of coccidia with morphology consistent with Eimeria spp.
The intestinal macrophage is the target cell for infection by M. a. paratuberculosis. After the organisms are ingested, they undergo endocytosis by intestinal M cells. Intact and degraded mycobacteria are transported in vacuoles across the M cells to macrophages in subepithelial areas. Specific macrophage receptors for this organism have not been identified, although other mycobacteria use complement receptor types 1 and 3 on macrophages. After uptake by macrophages, the bacteria often resist the degradative and killing mechanisms of the macrophage via sulphatide production, which prevents phagosome-lysosome fusion, escape from the phagosome into the cytoplasm, glycolipid-mediated inhibition of nitric oxide production, and inhibition of the respiratory burst and oxidative killing mechanisms by superoxide dismutase and glycolipid production.
In paratuberculosis, as in other mycobacterioses, cell-mediated
immunity is considered to be the principle mechanism for clearing
infection. Antibody is regarded to be of little use against intracellular
mycobacteria, and high serum antibody concentrations are often
seen in the presence of advanced clinical disease.3
Contributor: School of Veterinary Science, The University
of Melbourne, 250 Princes Highway, Werribee Vic 3030, Australia
References:
International Veterinary Pathology Slide Bank:
Laser disc frame #5012-3, 7112, 18606, 18689.
Terrell W. Blanchard
Major, VC, USA
Registry of Veterinary Pathology*
Department of Veterinary Pathology
Armed Forces Institute of Pathology
(202)782-2615; DSN: 662-2615
Internet: blanchard@email.afip.osd.mil
* The American Veterinary Medical Association and the American College of Veterinary Pathologists are co-sponsors of the Registry of Veterinary Pathology. The C.L. Davis Foundation also provides substantial support for the Registry.